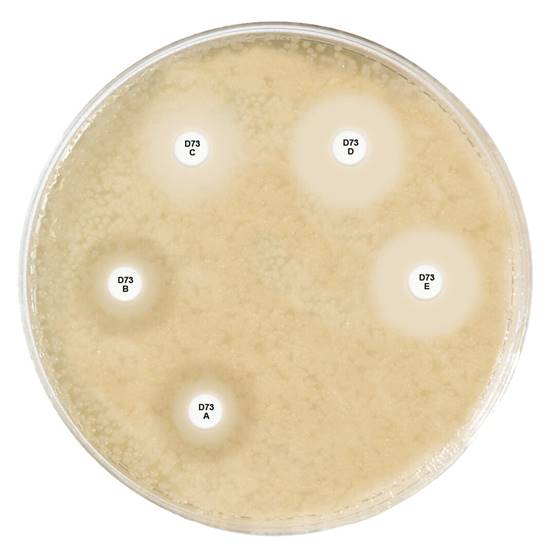
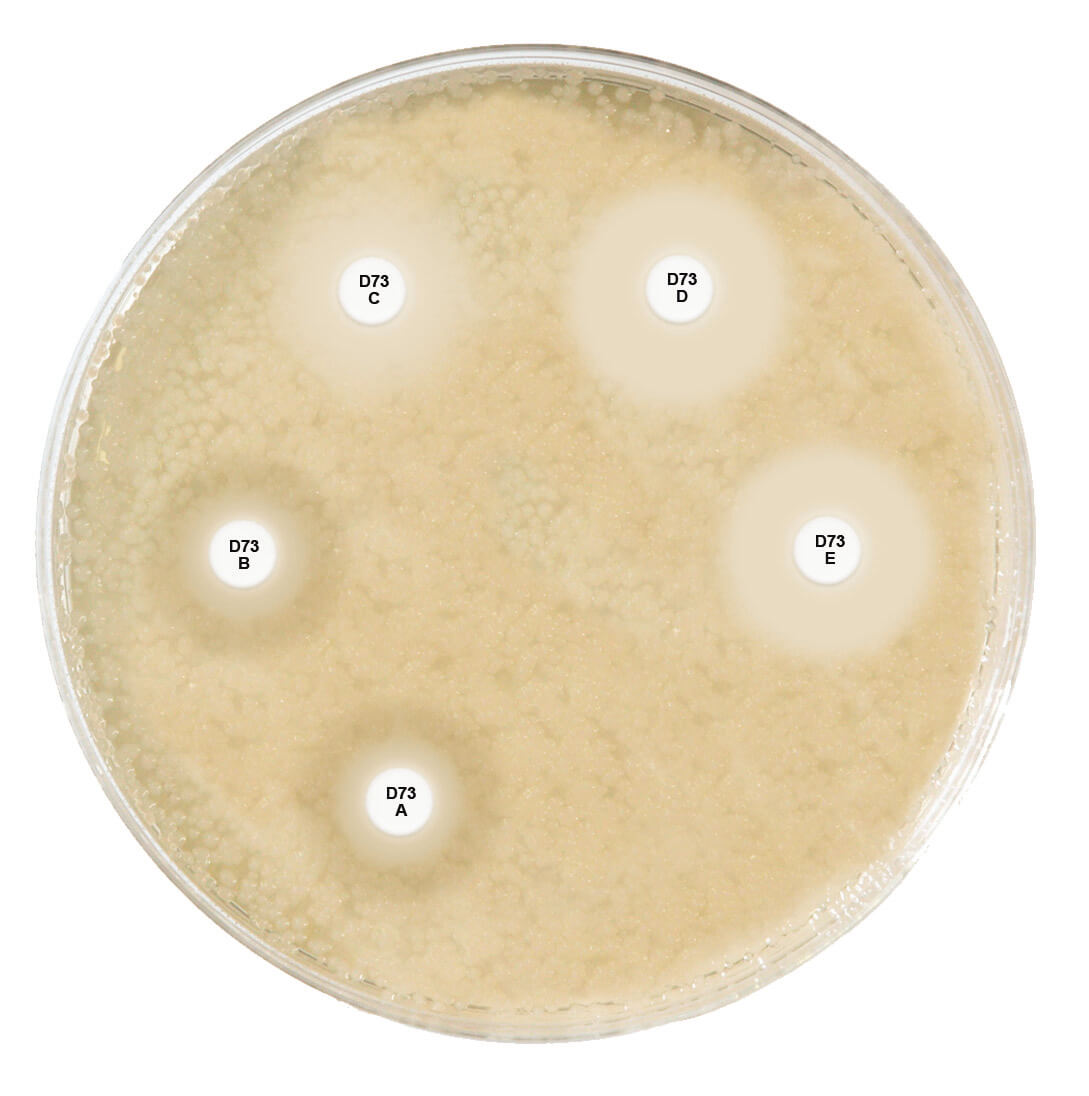
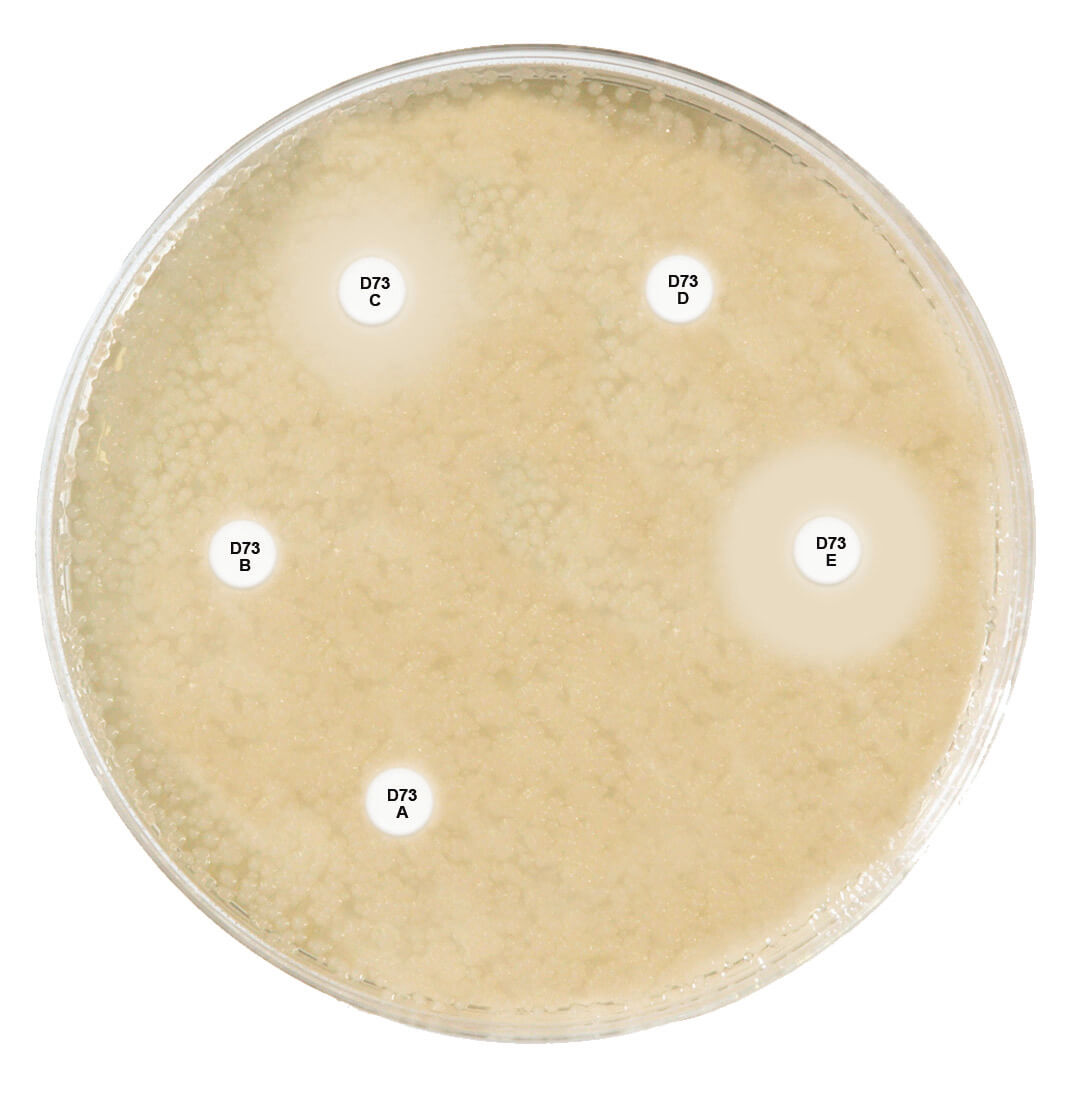
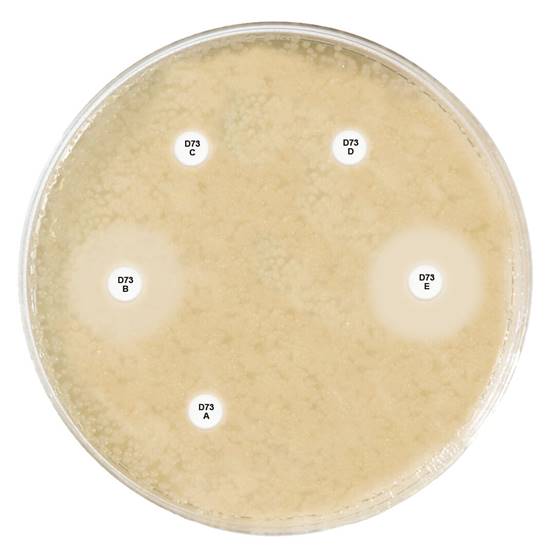
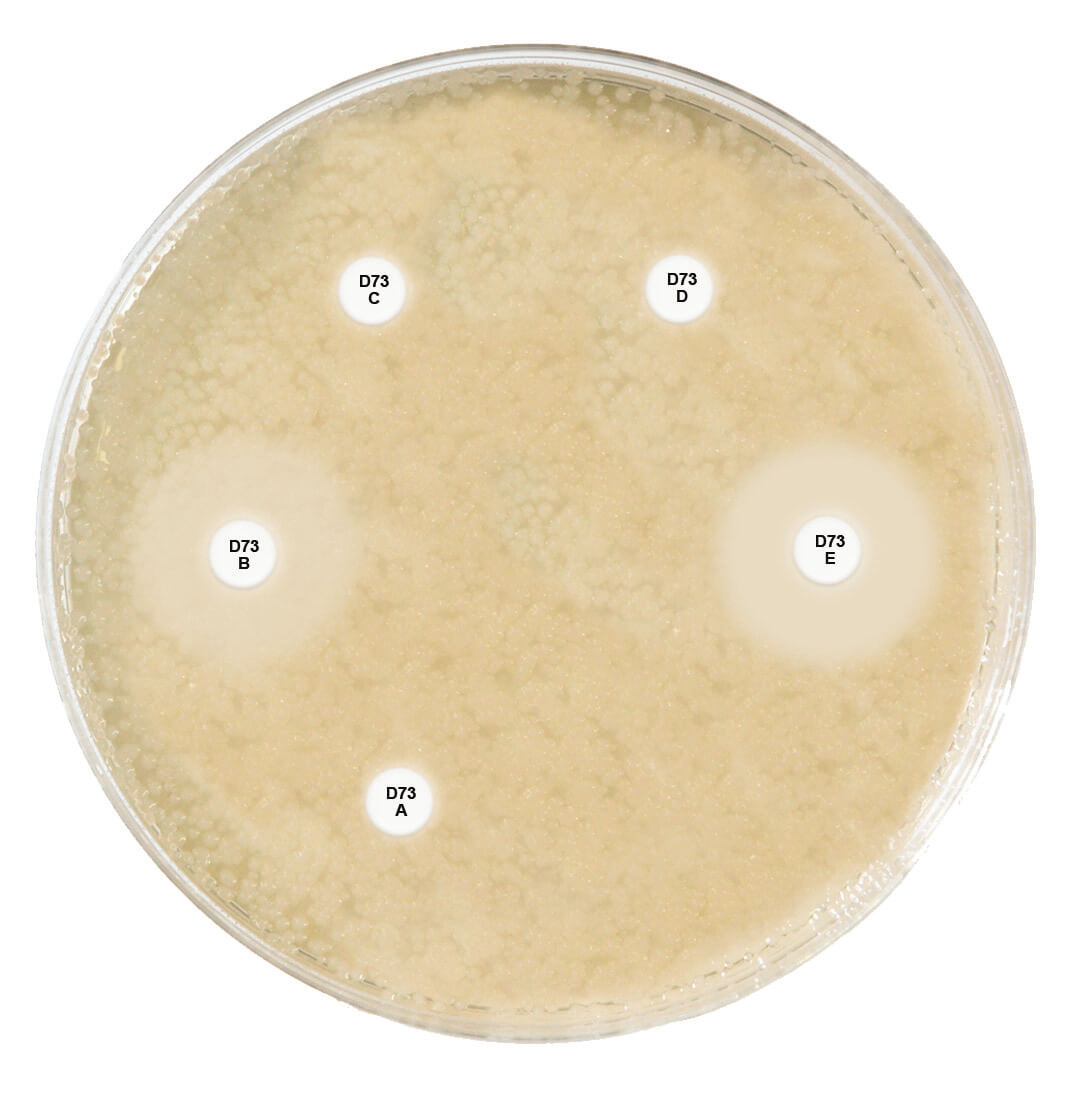
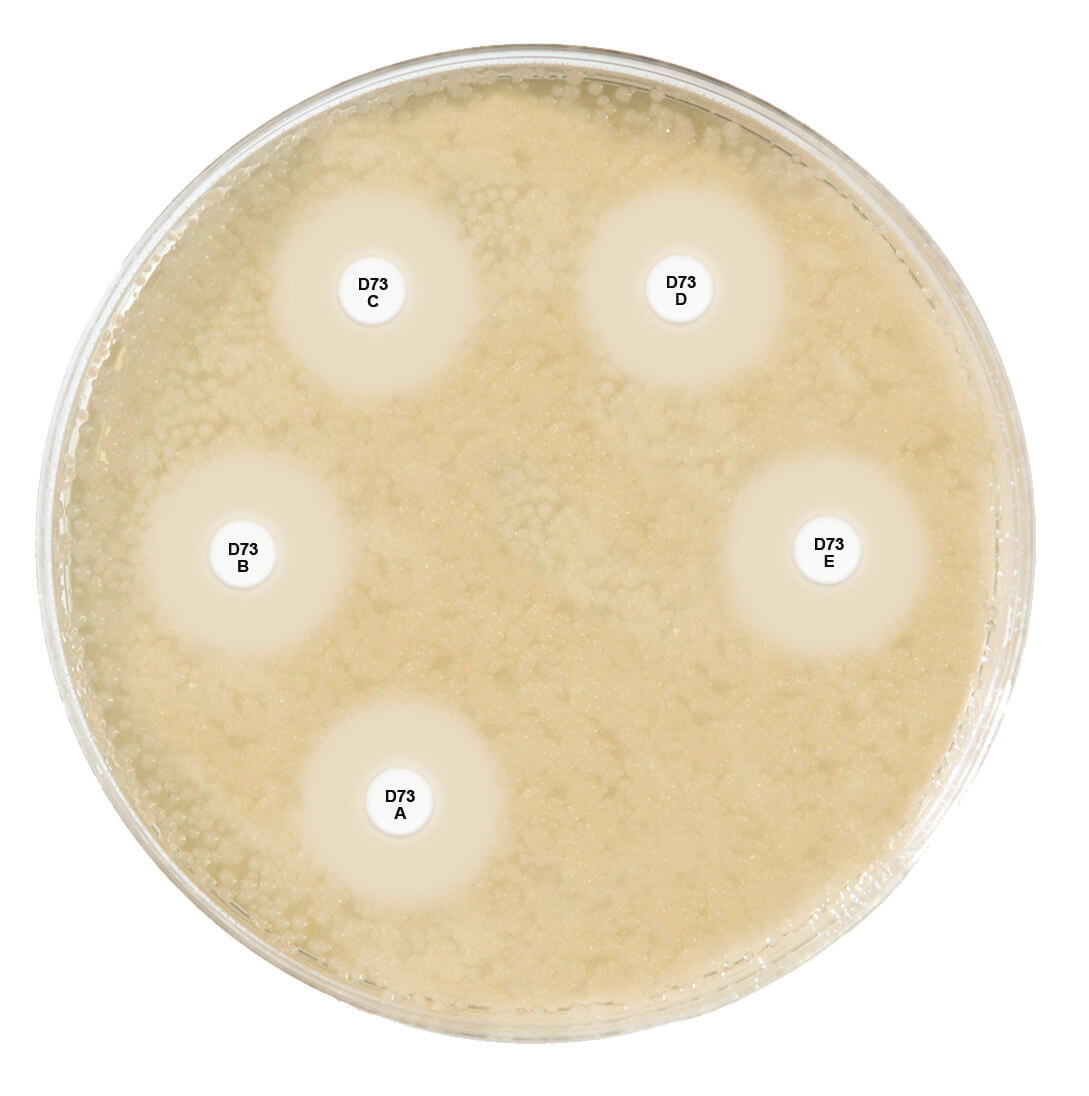
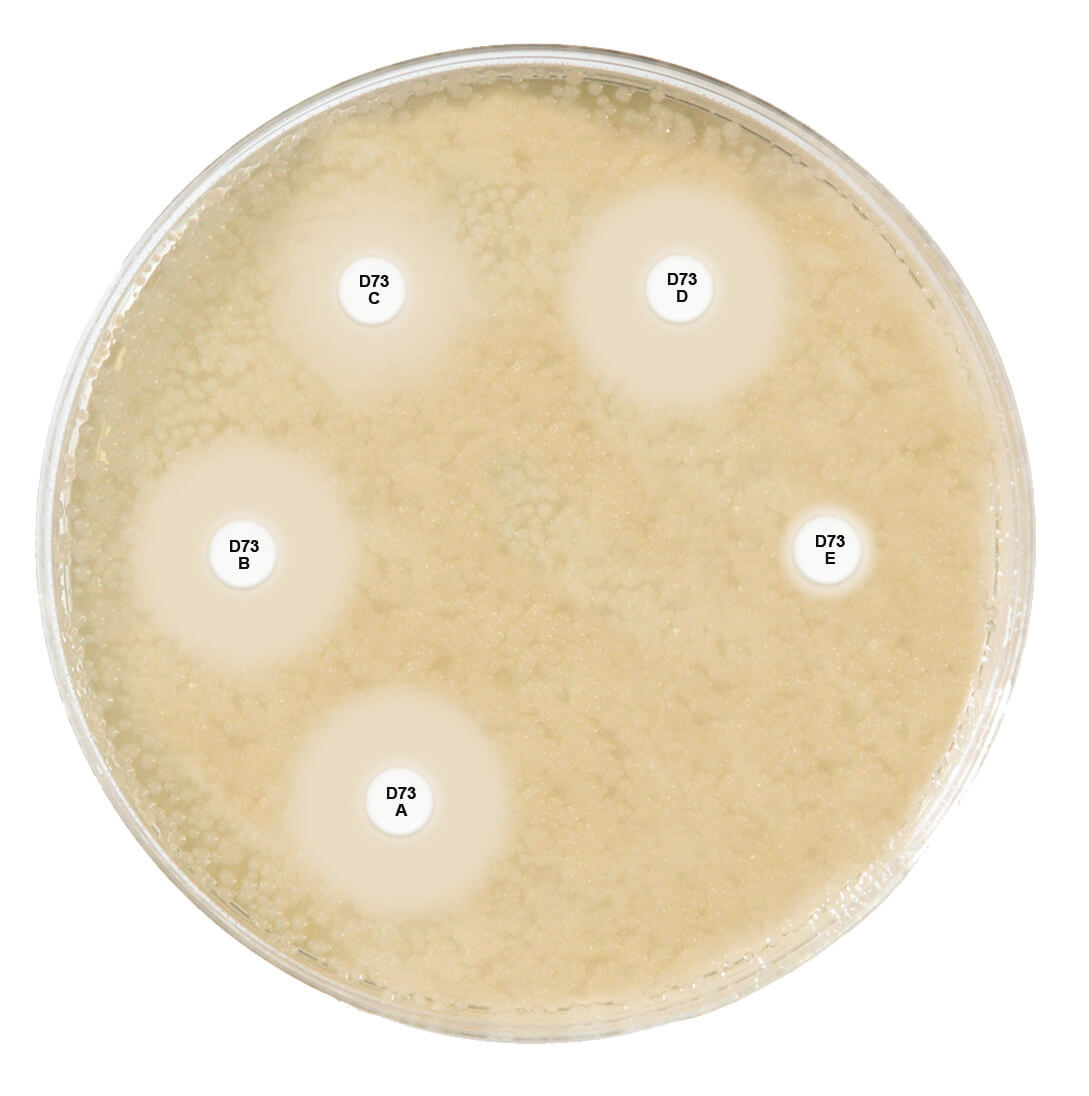
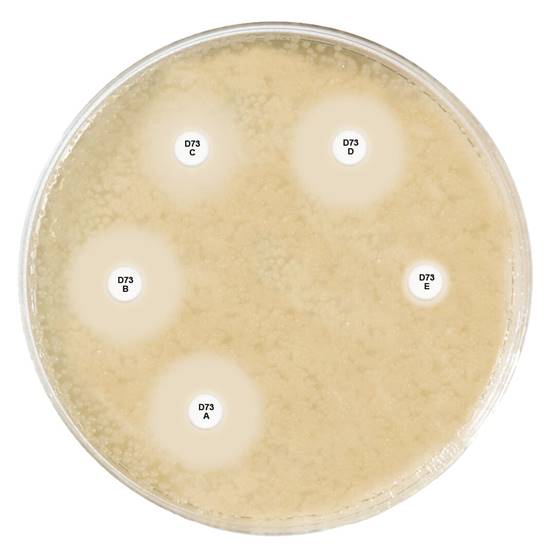

About the product
Five cartridges for the detection of carbapenemase and OXA-48-like enzyme production in Enterobacterales.
CARTRIDGE A: Penem discs
CARTRIDGE B: Penem + MβL inhibitor
CARTRIDGE C: Penem + KPC inhibitor
CARTRIDGE D: Penem + AmpC inhibitor
CARTRIDGE E: Temocillin + MβL inhibitor
NB: Please create an account or log in to download the calculator associated with this product from the 'General' tab above.